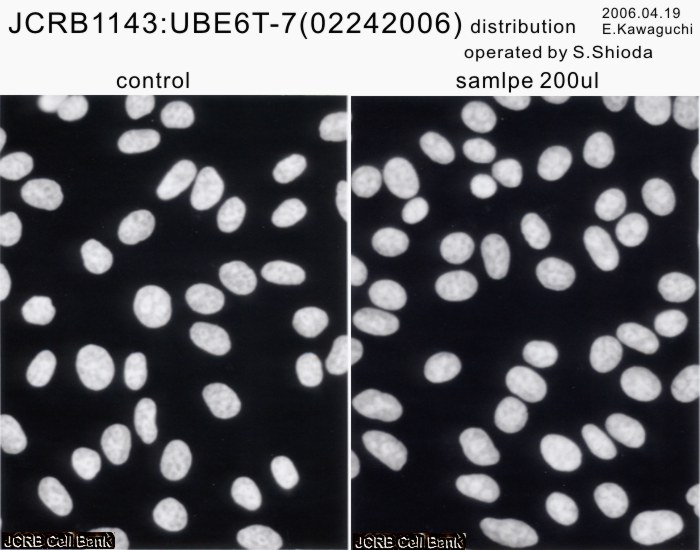
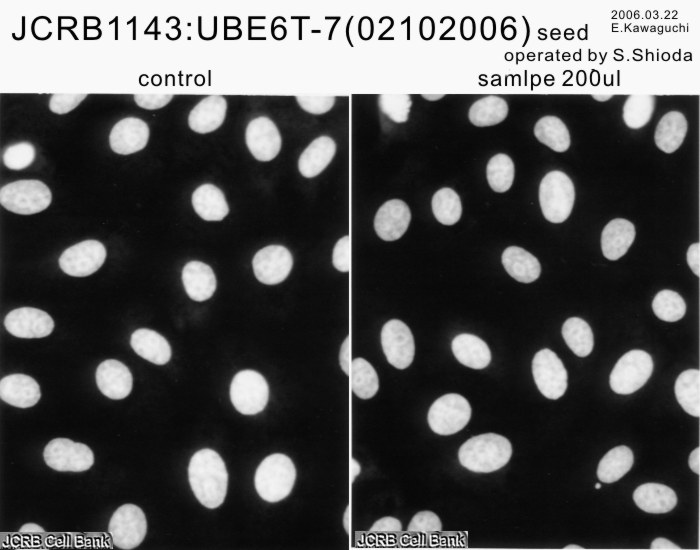

JCRB1143 UBE6T-7
Cell information
Important Notice(s)Cell type:general cells (View Pricing Information)
| JCRB No. | JCRB1143 | Cell Name | UBE6T-7 |
|---|---|---|---|
| Profile | Human bone marrow-derived mesenchymal stem cells. | Other Name | |
| Animal | human | Strain | |
| Genus | Homo | Species | sapiens |
| Sex | F | Age | 91 |
| Identity | available | Tissue for Primary Cancer | mesenchymal stem cell |
| Case history | Metastasis | No | |
| Tissue Metastasized | Genetics | Human bone marrow-derived mesenchymal stem cells which were infected with recombinant retroviruses expressing the bmi-1, E6, and hTERT. | |
| Life Span | infinite | Crisis PDL | |
| Morphology | fibroblast-like | Character | |
| Classify | normal | Established by | Umezawa, A. |
| Registered by | Umezawa, A. | Regulation for Distribution | |
| Comment | Year | 2005 | |
| Medium | Poweredby10 | Methods for Passages | When the cultures reached subconfluence, the cells were harvested with 0.25% trypsin and 1mM EDTA and replated with one-half of harvested cells. |
| Cell Number on Passage | Race | Japanese | |
| CO2 Conc. | 5% | Tissue Sampling | bone marrow |
| Tissue Type | bone marrow |
| Detection of virus genome fragment by Real-time PCR | |||||||||
|---|---|---|---|---|---|---|---|---|---|
| Detected DNA Virus | tested | Detected RNA Virus | tested | ||||||
| CMV | - | parvoB19 | - | HCV | - | HTLV-1 | - | ||
| EBV | - | HBV | - | HIV-1 | - | HTLV-2 | - | ||
| HHV6 | - | HTLV-1 | - | HIV-2 | - | HAV | - | ||
| HHV7 | - | HTLV-2 | - |
-/negative. +/positive. nt/not tested. (positive (+) does not immediately mean the production of infectious viral particles.) |
|||||
| BKV | - | HIV-1 | - | ||||||
| JCV | - | HIV-2 | - | ||||||
| ADV | - | HPV18 | - | ||||||
| Notes | |||||||||
| Reference | |
|---|---|
| Pubmed id:15923633 | Combination of hTERT and bmi-1, E6, or E7 induces prolongation of the life span of bone marrow stromal cells from an elderly donor without affecting their neurogenic potential. Mori T,Kiyono T,Imabayashi H,Takeda Y,Tsuchiya K,Miyoshi S,Makino H,Matsumoto K,Saito H,Ogawa S,Sakamoto M,Hata J,Umezawa A Mol Cell Biol. 2005 Jun;25(12):5183-95 |
| Pubmed id:15293342 | Can the life span of human marrow stromal cells be prolonged by bmi-1, E6, E7, and/or telomerase without affecting cardiomyogenic differentiation? Takeda Y,Mori T,Imabayashi H,Kiyono T,Gojo S,Miyoshi S,Hida N,Ita M,Segawa K,Ogawa S,Sakamoto M,Nakamura S,Umezawa A J Gene Med. 2004 Aug;6(8):833-45 |
| Images |
|---|
![]() ![]() ![]() ![]() ![]() ![]() ![]() ![]() ![]() ![]() ![]() ![]() ![]() ![]() ![]() ![]() ![]() ![]() |
| Movies |
|---|
|
|
LOT Information
Viability/Growth rate/Cell number are represented as actual values measured at lot presentation in JCRB, but are not guaranteed values. Additionally, the doubling time is a rough value measured during passages.| Cell No. | JCRB1143 | Cell Name | UBE6T-7 |
|---|---|---|---|
| LOT No. | 02242006 | Lot Specification | distribution |
| Medium | POWERDBY10 | Temperature | 37 C |
| Cell Density at Seeding | 3.3x10^3 cells/sq.cm | Methods for Passages | Cells were harvested after treatment with 0.25% trypsin and 1mM EDTA |
| Doubling Time | NT | Cell Number in Vial (cells/1ml) | 1.1x10^6 |
| Viability at cell freezing (%) | 96.8 | Antibiotics Used | |
| Passage Number | P52 | PDL | PD51 |
| Sterility: MYCOPLASMA | - | Sterility: BACTERIA | - |
| Sterility: FUNGI | - | Isozyme Analysis | G6PD(typeB),NP,LDH were examined.Human,not HeLa |
| Chromosome Mode | NT | Chromosome Information | NT |
| Surface Antigen | NT | DNA Profile (STR) | D5S818:10,13 D13S317:8 D7S820:8,11 D16S539:11,12 VWA:17,18 TH01:9 AM:X TPOX:11 CSF1PO:11,12 |
| Adhesion | Yes | Exoteric Gene | NT |
| Medium for Freezing | Cell Banker:BLC-1 | CO2 Conc. | 5 % |
| Viability immediately after thawing (%) | Additional information |
| Images |
|---|
![]() ![]() ![]() ![]() ![]() ![]() ![]() ![]() ![]() |
| Cell No. | JCRB1143 | Cell Name | UBE6T-7 |
|---|---|---|---|
| LOT No. | 12182017 | Lot Specification | distribution |
| Medium | POWEREDBY10(within serum and biotics) | Temperature | 37 C |
| Cell Density at Seeding | 3.5-4x10^3 cells/sq.cm | Methods for Passages | Cells were harvested after treatment with 0.25%trypsin(GIBCO) and 1mM EDTA.(Split ratio=1/4) |
| Doubling Time | NT | Cell Number in Vial (cells/1ml) | 1.81x10^6 |
| Viability at cell freezing (%) | 99.0 | Antibiotics Used | |
| Passage Number | p53 | PDL | 54.1 |
| Sterility: MYCOPLASMA | - | Sterility: BACTERIA | - |
| Sterility: FUNGI | - | Isozyme Analysis | NT |
| Chromosome Mode | NT | Chromosome Information | NT |
| Surface Antigen | NT | DNA Profile (STR) | D5S818:10,13 D13S317:8 D7S820:8,11 D16S539:11,12 VWA:17,18 TH01:9 AM:X TPOX:11 CSF1PO:11,12 |
| Adhesion | Yes | Exoteric Gene | NT |
| Medium for Freezing | Cell Banker BLC-1(Nihon Zenyaku Industries) | CO2 Conc. | 5% |
| Viability immediately after thawing (%) | NT | Additional information |
| Images |
|---|
|
|